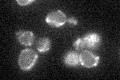
YIL098C
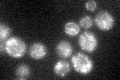
YIL098C

View description
Mitochondrial matrix protein, required for assembly or stability at high temperature of the F1 sector of mitochondrial F1F0 ATP synthase; null mutant temperature sensitive growth on glycerol is suppressed by multicopy expression of Odc1p
Localization:
Intensity:
Fold change:
Significance:
-
C’ GFP library in SD
mitochondria27.18 -
N' NOP1pr-GFP in SD

nucleus27.2701 -
N' TEF2pr-mCherry in SD

below threshold5.11614 -
N' NATIVEpr-GFP in SD

below threshold19.2718 -
N' TEF2pr-VC and Cyto-VN in SD

#N/A0 -
C’ GFP library in SD+DTT
mitochondria28.291.04No -
C’ GFP library in SD+H2O2

mitochondria22.530.82No -
C’ GFP library in Starvation Media

mitochondria45.231.66Yes -
C’ GFP library on the background of Pup2-DaMP

mitochondria -
C’ GFP library on the background of CCT mutant

mitochondria23.07620.848948No
